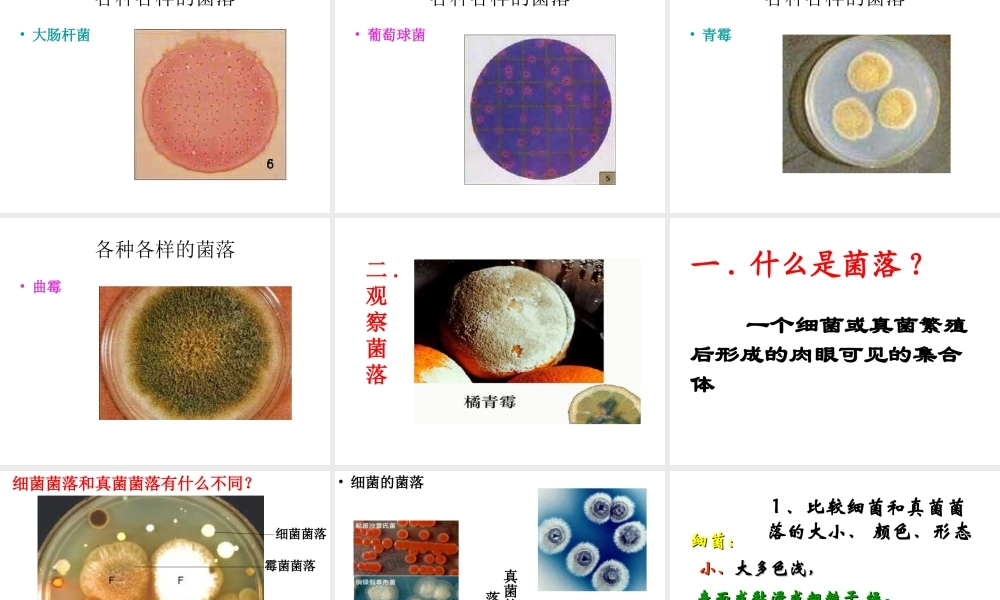
2014年秋八年级生物上册 第四章 第一节 细菌和真菌的分布课件4 新人教版
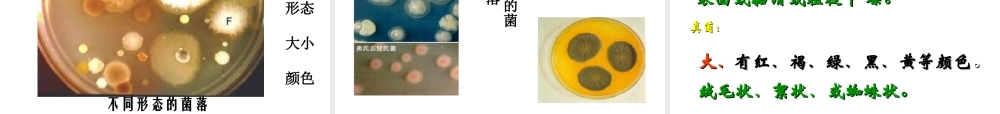
2014年秋八年级生物上册 第四章 第一节 细菌和真菌的分布课件4 新人教版

动物在自然界中的作用• 1 、在生态平衡中的重要作用• 2 、促进生态系统的物质循环• 3 、帮助植物传粉、传播种子和果实• 4 、其他作用 ( 如生物防治害虫、• 对植物或对动物造成危害、改善环境等)我们来复习一下吧:发霉桔子坏了的馒头变质牛奶•腐败的食物表面有白色小圆斑点,绿色斑点等•伤口会发炎•牛奶放久了会变质发酸 这些都是由于什么原因引起的
分布广泛的细菌和真菌 第 四 章 分布广泛的细菌和真菌第一节 细菌和真菌的分布背景:据调查报告:一根筷子上可能有 700 种细菌
每只脏手可携带 40 万细菌;而刚洗过的手,每平方厘米亦可检验出 3200 个细菌;在抽查的 700 张人民币上,竟有 440张检出代表肠道细菌污染的大肠杆菌;人的身体各个部位的皮肤表面,也携带着大量细菌,每 1 平方厘米面积的皮肤表面大约含有 1 ~ 10 万个细菌 , 一个指甲缝里有近 5万个细菌
那么,细菌和真菌都能分布在什么环境中呢
说出细菌和真菌分布的特点
尝试采用细菌和真菌培养的一般方法,探究细菌和真菌的分布
积极参加探究方案的制定,在与小组成员共同完成实验的过程中,及时相互交流经验,体验与他人合作完成探究活动
思 考思 考馒头存放时间久了为什么会长毛
腐烂的树枝怎么会长有木耳呢
营养丰富的牛奶和米饭为什么变质了
馒头发霉树生木耳空气中有许多细菌和真菌,那请同学们帮忙“抓”100 个细菌过来给我
这个任务可能完成吗
因为细菌太小了
菌落细菌太小了,观察细菌要用光学显微镜或电子显微镜放大几百倍到上千倍才能看到
观 察 菌 落观 察 菌 落怎样才能用肉眼看到手上的细菌
一个细菌或真菌繁殖后形成的肉眼可见的集合体
链球菌各种各样的菌落• 大肠杆菌各种各样的菌落• 葡萄球菌各种各样的菌落• 青霉各种各样的菌落• 曲霉二